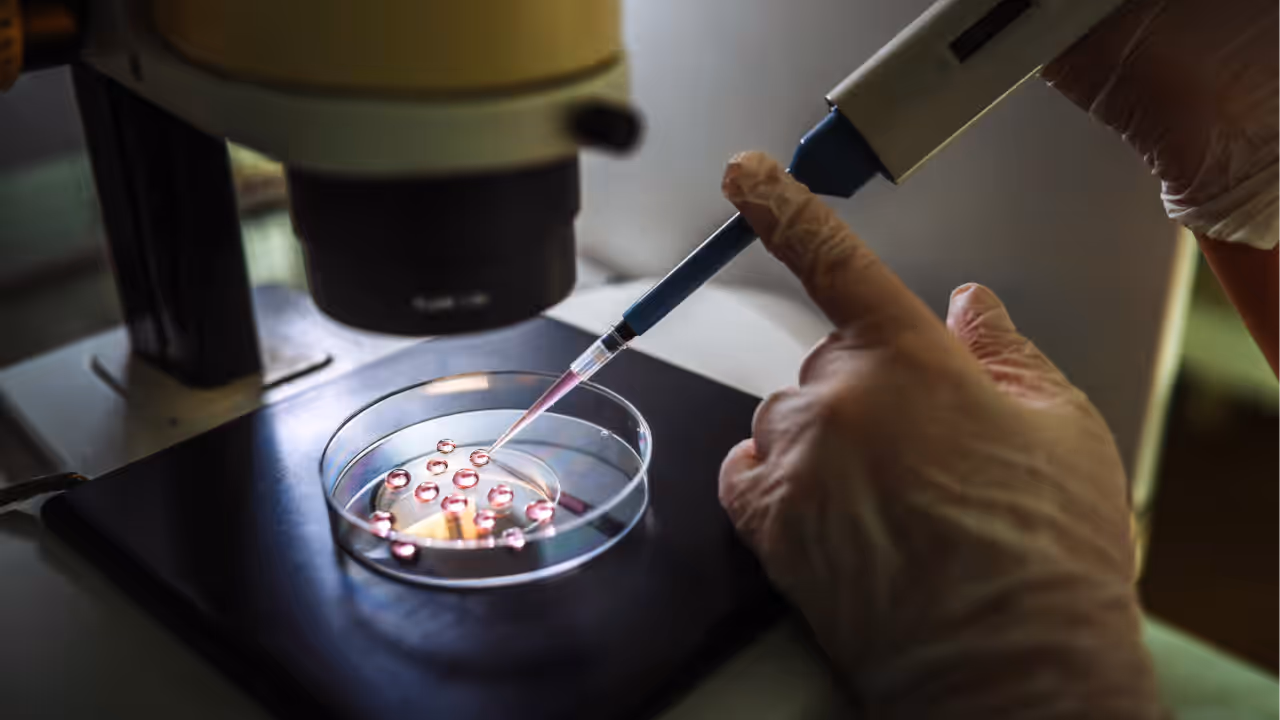
IVF treatment IVF treatment

Discover how new AI tools are revolutionizing IVF by selecting the most viable embryos. Learn how this tech boosts success rates while raising key ethical questions.
Paris, France - Artificial intelligence tools can now help choose the most promising embryos for in vitro fertilisation (IVF), although experts have warned of some ethical concerns.

Procedures such as IVF allow millions of children to be born across the world each year to parents who have otherwise struggled to conceive.
However the success rate of the procedure, which involves creating an embryo by fertilising an egg with sperm in the lab, can vary widely and declines with age.
Now, almost 50 years after the first IVF child was born, "artificial intelligence is here to help us select better embryos or at least help determine their potential for implantation", Nathalie Massin, the head of the clinical unit of an IVF centre at the American Hospital of Paris, told AFP.
The facility in the French capital carries out more than 2,300 IVF procedures every year. It is equipped with an embryoscope, which works as a time-lapse camera that continuously films the development of the embryos.
The data recorded by the camera -- such as the shape, symmetry and cell division of the embryo -- had previously only been used to a limited extent.
But tools using AI such as machine learning have been shown to help doctors select the embryos that have the best chance of being successfully implanted or frozen for later.
This would reduce the number of costly IVF attempts for hopeful parents by ruling out the embryos most likely to have abnormalities which lead to miscarriages.
AI tools can do this without manipulating the embryos, so it is not related to concerns about genetically engineered "designer babies".
- 'Avoid the emotional rollercoaster' -
Frida Entezami, co-leader of the IVF department at the American Hospital of Paris, emphasised that "humans will continue to make the decisions but with this additional tool".
The hospital acquired its AI from Israeli start-up AIVF. The tool is currently being tested internally with the aim of "halving the number of cycles needed to achieve pregnancy", Entezami said.
"AIVF will offer a 70-percent probability that the embryo it recommends will not have genetic abnormalities," Entezami said.
That is a "significant improvement" given that currently around half of pre-implantation embryos have such abnormalities, she added.
Tools harnessing AI can also help adjust the timing and dosage of hormone injections before collecting eggs, and increase the chance of finding sperm in a sample with a low number.
Anne-Claire Lepretre, head of the assisted reproductive technologies (ART) unit at France's Biomedicine Agency, told AFP that the algorithms are tested to ensure they are using the correct data.
Because "unfortunately ART does not always work the first time", lots of information from a failed attempt can be fed into AI models to increase the chances of success in the future, she added.
Such "personalised" assistance for hopeful parents could "avoid the emotional rollercoaster" of these "long, complex and often psychologically difficult" journeys, Lepretre said.
- Opt out option for AI sceptics? -
However other researchers have urged caution.
"The use of AI in embryo selection means that computer algorithms are beginning to make decisions about who is brought into the world," said Julian Koplin, a bioethicist at Australia's Monash University who led a recent review of the practice.
"We argue that since some patients may have genuine moral objections to the use of AI to make decisions about which children they have, they should be informed about its use, and should ideally be able to opt out," Koplin said in a statement.
The review, published in the journal Human Reproduction earlier this year, called for more scrutiny but found that the "ethical concerns do not amount to arguments against the use" of AI tools for embryo assessment.
"There is a lot of talk about AI," Michael Grynberg, a French obstetrician-gynaecologist specialising in IVF, told AFP.
"We need more relevant markers because those related to the morphology of an egg or sperm are not sufficient," he added.
pan/dl/phz
© Agence France-Presse
(Except for the headline, this story has not been edited by Asianet Newsable English staff and is published from a syndicated feed.)